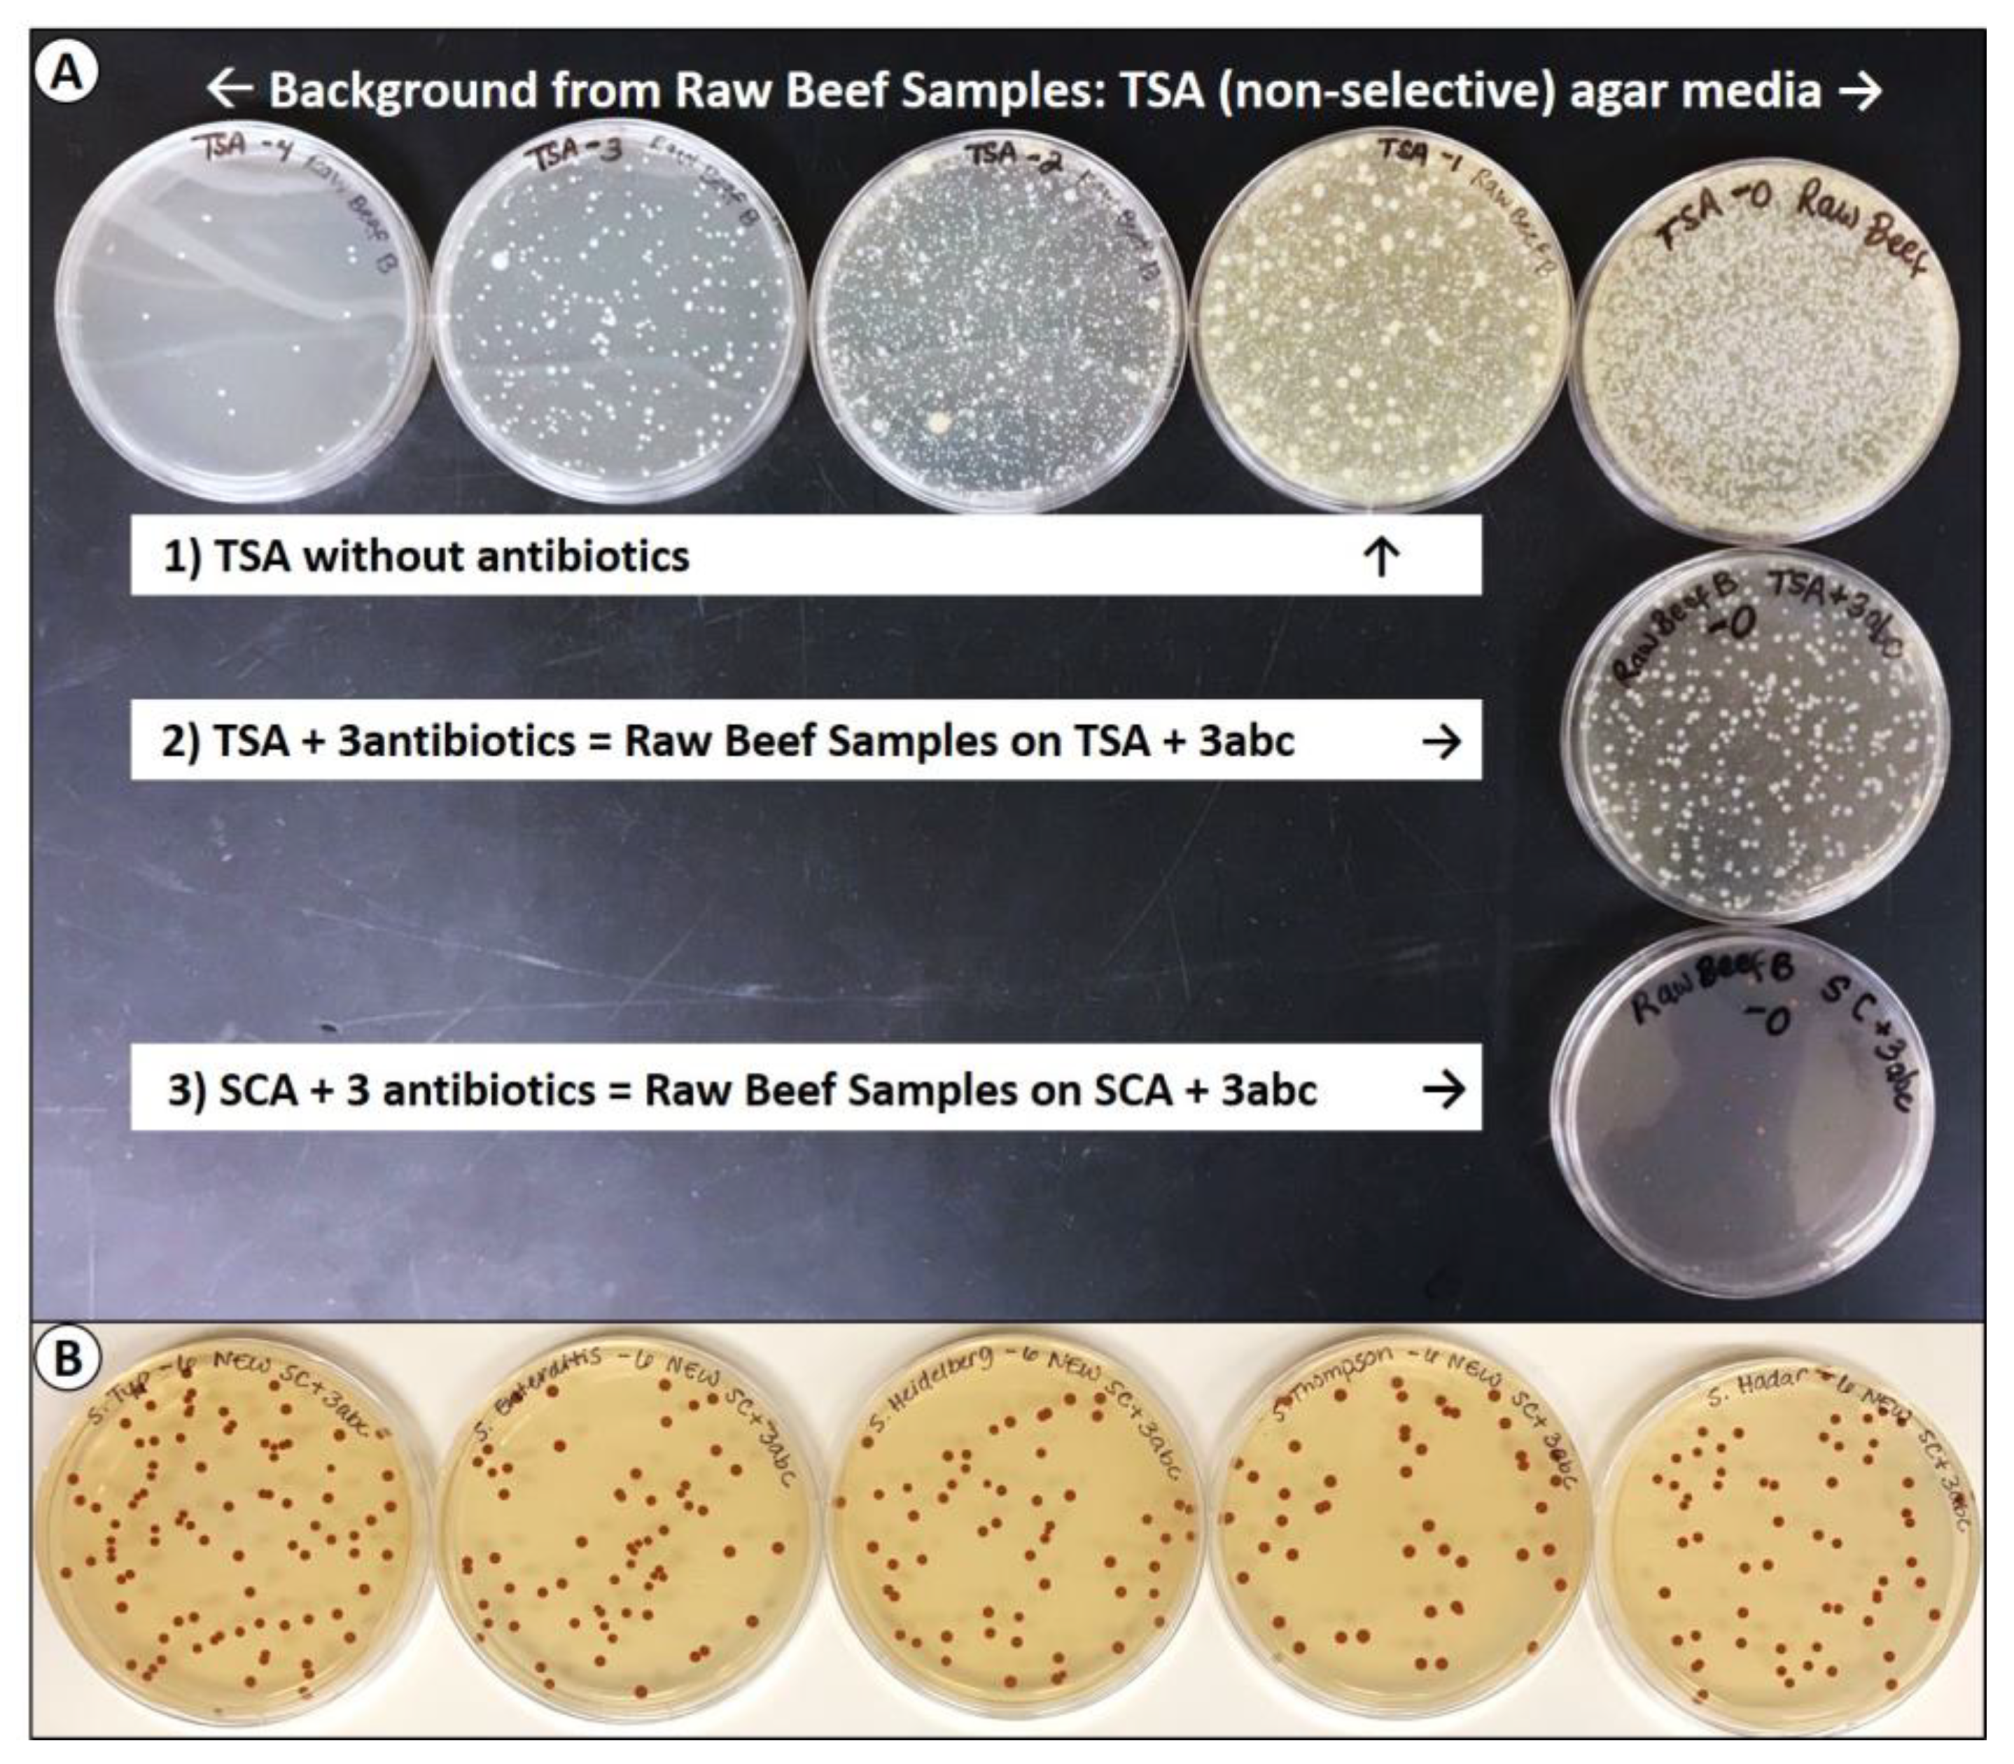
Microorganisms 08 00338 g004 Microorganisms 08 00338 g004

Selenite Cystine Agar for Enumeration of Inoculated Salmonella Serovars Recovered from Stressful Conditions during Antimicrobial Validation Studies
Abstract
1. Introduction
2. Materials and Methods
2.1. Bacterial Strains and Growth Conditions
2.2. Antibiotics, Disc Assay, and Media Validation of Antibiotic Resistance
2.3. Salmonella-Selective Agar Media Used for Enumeration of Salmonella spp. after Stressed Conditions
2.4. Preliminary Studies: Evaluation of Sodium Pyruvate for Recovery of Injured Bacterial Cells
2.4.1. Sodium Pyruvate Following Acid Adaptation and Nutrient Starvation
2.4.2. Sodium Pyruvate Following Acid Adaptation, Salt Desiccation, and Acid Exposure
2.5. Stress Conditions for Enumeration
2.5.1. Nutrient Depletion and Cell Starvation
2.5.2. Antimicrobial (Acid) Stress
2.5.3. Desiccation and Drying
2.5.4. Thermal Stress
2.6. Bacterial Injury
2.7. Statistical Analysis
3. Results
3.1. Acid Adaptation of Salmonella Cultures
3.2. Determination of Salmonella Antibiotic Resistance (Disc Assay)
3.3. Confirmation of Salmonella Antibiotic Resistance (Plating on Agar Containing Antibiotics)
3.4. Selective Agar Media Containing Antibiotics
Tryptic Soy Agar and Selenite Cystine Agar Containing Antibiotics
3.5. Comparitive Enumeration on Selective Agars with and without Sodium Pyruvate
Evaluation of Sodium Pyruvate for Recovery of Injured Cells
3.6. Salmonella Stress Conditions: Nutrient Depletion and Starvation
3.7. Salmonella Stress Conditions: Exposure to Acidic Antimicrobials
3.8. Salmonella Stress Conditions: Desiccation and Drying
3.9. Salmonella Stress Conditions: Thermal Stress
3.10. Bacterial Injury as Determined by Plating on Selective vs. Nonselective Media
4. Discussion
5. Conclusions
Author Contributions
Funding
Conflicts of Interest
References
- Knopp, M.; Andersson, D.I. Predictable phenotypes of antibiotic resistance mutations. mBio 2018, 9, e00770-18. [Google Scholar] [CrossRef] [PubMed]
- Sun, J.; Zhu, D.; Xu, J.; Jia, R.; Chen, S.; Liu, M.; Zhao, X.; Yang, Q.; Wu, Y.; Zhang, S.; et al. Rifampin resistance and its fitness cost in Riemerella anatipestifer. BMC Microbiol. 2019, 19, 107. [Google Scholar] [CrossRef] [PubMed]
- Woodford, N.; Ellington, M.J. The emergence of antibiotic resistance by mutation. Clin. Microbiol. Infect. 2007, 13, 5–18. [Google Scholar] [CrossRef] [PubMed]
- Muriana, P.M.; Klaenhammer, T.R. Conjugal transfer of plasmid-encoded determinants for bacteriocin production and immunity in Lactobacillus acidophilus 88. Appl. Environ. Microbiol. 1987, 53, 553–560. [Google Scholar] [CrossRef] [PubMed]
- Mann, J.E.; Brashears, M.M. Validation of time and temperature values as critical limits for the control of Escherichia coli O157:H7 during the production of fresh ground beef. J. Food Prot. 2006, 69, 1978–1982. [Google Scholar] [CrossRef]
- Price, S.B.; Cheng, C.M.; Kaspar, C.W.; Wright, J.C.; Degraves, F.J.; Penfound, T.A.; Castanie-Cornet, M.P.; Foster, J.W. Role of rpoS in acid resistance and fecal shedding of Escherichia coli O157:H7. Appl. Environ. Microbiol. 2000, 66, 632–637. [Google Scholar] [CrossRef]
- Luchansky, J.B.; Porto-Fett, A.C.S.; Shoyer, B.; Phebus, R.K.; Thippareddi, H.; Call, J.E. Thermal inactivation of Escherichia coli O157:H7 in blade-tenderized beef steaks cooked on a commercial open-flame gas grill. J. Food Prot. 2009, 72, 1404–1411. [Google Scholar] [CrossRef]
- Flores, R.A. Distribution of Escherichia coli O157:H7 in beef processed in a table-top bowl cutter. J. Food Prot. 2004, 67, 246–251. [Google Scholar] [CrossRef]
- National Advisory Committee on the Microbiological Criteria for Foods. Parameters for determining inoculated pack/challenge study protocols. J. Food Prot. 2010, 73, 140–202. [Google Scholar] [CrossRef]
- Pao, S.; Kalantari, A.; Huang, G. Utilizing acidic sprays for eliminating Salmonella enterica on raw almonds. J. Food Sci. 2006, 71, M14–M19. [Google Scholar] [CrossRef]
- Gorski, L. Selective enrichment media bias the types of Salmonella enterica strains isolated from mixed strain cultures and complex enrichment broths. PLoS ONE 2012, 7, e34722. [Google Scholar] [CrossRef]
- Martin, S.E.; Flowers, R.S.; Ordal, Z.J. Catalase: Its effect on microbial enumeration. Appl. Environ. Microbiol. 1976, 32, 731–734. [Google Scholar] [CrossRef] [PubMed]
- Mcdonald, L.C.; Hackney, C.R.; Ray, B. Enhanced recovery of injured Escherichia coli by compounds that degrade hydrogen peroxide or block its formation. Appl. Environ. Microbiol. 1983, 45, 360–365. [Google Scholar] [CrossRef] [PubMed]
- Shi, H.; Zhang, R.; Lan, L.; Chen, Z.; Kan, J. Zinc mediates resuscitation of lactic acid-injured Escherichia coli by relieving oxidative stress. J. Appl. Microbiol. 2019, 127, 1741–1750. [Google Scholar] [CrossRef] [PubMed]
- Jacobson, A.P.; Wang, H.; Gill, V.S.; Duvall, R.; Arce, G.; Chirtel, S.; Hammack, T.S. Relative effectiveness of selected preenrichment media for the detection of Salmonella from leafy green produce and herbs. Food Microbiol. 2017, 63, 123–128. [Google Scholar] [CrossRef] [PubMed]
- Williams, M.S.; Ebel, E.D.; Hretz, S.A.; Golden, N.J. Adoption of neutralizing buffered peptone water coincides with changes in apparent prevalence of Salmonella and Campylobacter of broiler rinse samples. J. Food Prot. 2018, 81, 1851–1863. [Google Scholar] [CrossRef]
- Yan, Z.; Gurtler, J.B.; Kornacki, J.L. A solid agar overlay method for recovery of heat-injured Listeria monocytogenes. J. Food Prot. 2006, 69, 428–431. [Google Scholar] [CrossRef]
- Kang, D.H.; Fung, D.Y.C. Thin agar layer method for recovery of heat-injured Listeria monocytogenes. J. Food Prot. 1999, 62, 1346–1349. [Google Scholar] [CrossRef]
- Kang, D.H.; Fung, D.Y.C. Application of thin agar layer method for recovery of injured Salmonella Typhimurium. Int. J. Food Microbiol. 2000, 54, 127–132. [Google Scholar] [CrossRef]
- Wu, V.C.H.; Fung, D.Y.C.; Kang, D.H.; Thompson, L.K. Evaluation of thin agar layer method for recovery of acid-injured foodborne pathogens. J. Food Prot. 2001, 64, 1067–1071. [Google Scholar] [CrossRef]
- Kang, D.H.; Siragusa, G.R. Agar underlay method for recovery of sublethally hheat-injured bacteria. Appl. Environ. Microbiol. 1999, 65, 5334–5337. [Google Scholar] [CrossRef]
- Juneja, V.K.; Hwang, C.A.; Friedman, M. Thermal inactivation and postthermal treatment growth during storage of multiple Salmonella serotypes in ground beef as affected by sodium lactate and oregano oil. J. Food Sci. 2010, 75, M1–M6. [Google Scholar] [CrossRef] [PubMed]
- Carpenter, C.E.; Smith, J.V.; Broadbent, J.R. Efficacy of washing meat surfaces with 2% levulinic, acetic, or lactic acid for pathogen decontamination and residual growth inhibition. Meat Sci. 2011, 88, 256–260. [Google Scholar] [CrossRef]
- Juneja, V.K.; Eblen, B.S.; Marks, H.M. Modeling non-linear survival curves to calculate thermal inactivation of Salmonella in poultry of different fat levels. Int. J. Food Microbiol. 2001, 70, 37–51. [Google Scholar] [CrossRef]
- Juneja, V.K.; Yadav, A.S.; Hwang, C.A.; Sheen, S.; Mukhopadhyay, S.; Friedman, M. Kinetics of thermal destruction of Salmonella in ground chicken containing trans-cinnamaldehyde and carvacrol. J. Food Prot. 2012, 75, 289–296. [Google Scholar] [CrossRef] [PubMed]
- Wilde, S.; Jørgensen, F.; Campbell, A.; Rowbury, R.; Humphrey, T. Growth of Salmonella enterica Serovar Enteritidis PT4 in media containing glucose results in enhanced RpoS-independent heat and acid tolerance but does not affect the ability to survive air-drying on surfaces. Food Microbiol. 2000, 17, 679–686. [Google Scholar] [CrossRef]
- Calicioglu, M.; Sofos, J.N.; Samelis, J.; Kendall, P.A.; Smith, G.C. Effect of acid adaptation on inactivation of Salmonella during drying and storage of beef jerky treated with marinades. Int. J. Food Microbiol. 2003, 89, 51–65. [Google Scholar] [CrossRef]
- Sandle, T. 14—Antibiotics and preservatives. In Pharmaceutical Microbiology; Sandle, T., Ed.; Woodhead Publishing: Oxford, UK, 2016; pp. 171–183. [Google Scholar]
- Lee, R.M.; Hartman, P.A. Optimal pyruvate concentration for the recovery of coliforms from food and water. J. Food Prot. 1989, 52, 119–121. [Google Scholar] [CrossRef]
- Morishige, Y.; Fujimori, K.; Amano, F. Differential resuscitative effect of pyruvate and its analogues on VBNC (viable but non-culturable) Salmonella. Microbes Environ. 2013, 28, 180–186. [Google Scholar] [CrossRef]
- Gurtler, J.B.; Beuchat, L.R. Performance of media for recovering stressed cells of Enterobacter sakazakii as determined using spiral plating and ecometric techniques. Appl. Environ. Microbiol. 2005, 71, 7661–7669. [Google Scholar] [CrossRef]
- Wesche, A.M.; Marks, B.P.; Ryser, E.T. Thermal resistance of heat-, cold-, and starvation-injured Salmonella in irradiated comminuted Turkey. J. Food Prot. 2005, 68, 942–948. [Google Scholar] [CrossRef]
- Dickson, J.S.; Frank, J.F. Bacterial starvation stress and contamination of beef. Food Microbiol. 1993, 10, 215–222. [Google Scholar] [CrossRef]
- Bollenbach, T. Antimicrobial interactions: Mechanisms and implications for drug discovery and resistance evolution. Curr. Opin. Microbiol. 2015, 27, 1–9. [Google Scholar] [CrossRef] [PubMed]
- Ocampo, P.S.; Lázár, V.; Papp, B.; Arnoldini, M.; Abel Zur Wiesch, P.; Busa-Fekete, R.; Fekete, G.; Pál, C.; Ackermann, M.; Bonhoeffer, S. Antagonism between bacteriostatic and bactericidal antibiotics is prevalent. Antimicrob. Agents Chemother. 2014, 58, 4573–4582. [Google Scholar] [CrossRef]
- Singh, N.; Yeh, P.J. Suppressive drug combinations and their potential to combat antibiotic resistance. J. Antibiot. 2017, 70, 1033–1042. [Google Scholar] [CrossRef] [PubMed]
- Yilancioglu, K. Antimicrobial drug interactions: Systematic evaluation of protein and nucleic acid synthesis inhibitors. Antibiotics 2019, 8, 114. [Google Scholar] [CrossRef] [PubMed]
- Tuntivanich, V.; Orta-Ramirez, A.; Marks, B.P.; Ryser, E.T.; Booren, A.M. Thermal inactivation of Salmonella in whole muscle and ground turkey breast. J. Food Prot. 2008, 71, 2548–2551. [Google Scholar] [CrossRef] [PubMed]
- Velasquez, A.; Breslin, T.J.; Marks, B.P.; Orta-Ramirez, A.; Hall, N.O.; Booren, A.M.; Ryser, E.T. Enhanced thermal resistance of Salmonella in marinated whole muscle compared with ground pork. J. Food Prot. 2010, 73, 372–375. [Google Scholar] [CrossRef] [PubMed]
- Orta-Ramirez, A.; Marks, B.P.; Warsow, C.R.; Booren, A.M.; Ryser, E.T. Enhanced thermal resistance of Salmonella in whole muscle compared to ground beef. J. Food Sci. 2005, 70, m359–m362. [Google Scholar] [CrossRef]
- Warsow, C.R.; Orta-Ramirez, A.; Marks, B.P.; Ryser, E.T.; Booren, A.M. Single directional migration of Salmonella into marinated whole muscle turkey breast. J. Food Prot. 2008, 71, 153–156. [Google Scholar] [CrossRef]
- Mann, J.E.; Brashears, M.M. Contribution of humidity to the lethality of surface-attached heat-resistant Salmonella during the thermal processing of cooked ready-to-eat roast beef. J. Food Prot. 2007, 70, 762–765. [Google Scholar] [CrossRef] [PubMed]
- Foster, J.W. Salmonella acid shock proteins are required for the adaptive acid tolerance response. J. Bacteriol. 1991, 173, 6896–6902. [Google Scholar] [CrossRef] [PubMed]
- Leyer, G.J.; Johnson, E.A. Acid adaptation promotes survival of Salmonella spp. in cheese. Appl. Environ. Microbiol. 1992, 58, 2075–2080. [Google Scholar] [CrossRef] [PubMed]
- Foster, J.W.; Hall, H.K. Adaptive acidification tolerance response of Salmonella typhimurium. J. Bacteriol. 1990, 172, 771–778. [Google Scholar] [CrossRef]
- Buchanan, R.L.; Edelson, S.G. Culturing enterohemorrhagic Escherichia coli in the presence and absence of glucose as a simple means of evaluating the acid tolerance of stationary-phase cells. Appl. Environ. Microbiol. 1996, 62, 4009–4013. [Google Scholar] [CrossRef]
- Buchanan, R.L.; Golden, M.H.; Whiting, R.C.; Phillips, J.G.; Smith, J.L. Non-thermal inactivation models for Listeria monocytogenes. J. Food Sci. 1994, 59, 179–188. [Google Scholar] [CrossRef]
- Álvarez-Ordóñez, A.; Prieto, M.; Bernardo, A.; Hill, C.; López, M. The acid tolerance response of Salmonella spp.: An adaptive strategy to survive in stressful environments prevailing in foods and the host. Food Res. Intl. 2012, 45, 482–492. [Google Scholar] [CrossRef]
- Suehr, Q.J.; Chen, F.; Anderson, N.M.; Keller, S.E. Effect of pH on survival of Escherichia coli O157, Escherichia coli O121, and Salmonella enterica during desiccation and short-term storage. J. Food Prot. 2020, 83, 211–220. [Google Scholar] [CrossRef]
- Knabel, S.J.; Thielen, S.A. Enhanced recovery of severely heat-injured, thermotolerant Listeria monocytogenes from USDA and FDA primary enrichment media using a novel, simple, strictly anaerobic method. J. Food Prot. 1995, 58, 29–34. [Google Scholar] [CrossRef]
- Kirby, R.M.; Davies, R. Survival of dehydrated cells of Salmonella typhimurium LT2 at high temperatures. J. Appl. Bacteriol. 1990, 68, 241–246. [Google Scholar] [CrossRef] [PubMed]
- Leyer, G.J.; Johnson, E.A. Acid adaptation induces cross-protection against environmental stresses in Salmonella typhimurium. Appl. Environ. Microbiol. 1993, 59, 1842–1847. [Google Scholar] [CrossRef] [PubMed]
- Greenacre, E.J.; Brocklehurst, T.F. The acetic acid tolerance response induces cross-protection to salt stress in Salmonella typhimurium. Intl. J. Food Microbiol. 2006, 112, 62–65. [Google Scholar] [CrossRef] [PubMed]
- Bacon, R.T.; Ransom, J.R.; Sofos, J.N.; Kendall, P.A.; Belk, K.E.; Smith, G.C. Thermal iinactivation of susceptible and multiantimicrobial-resistant Salmonella strains grown in the absence or presence of glucose. Appl. Environ. Microbiol. 2003, 69, 4123–4128. [Google Scholar] [CrossRef] [PubMed][Green Version]
- Strantz, A.A.; Zottola, E.A. A modified plating technique for the recovery and enumeration of stressed Salmonella typhimurium Hf. J. Food Prot. 1989, 52, 712–714. [Google Scholar] [CrossRef] [PubMed]
- Ferreira, F.S.; Horvath, M.B.; Tondo, E.C. Assessing the growth and recovery of Salmonella Enteritidis SE86 after sodium dichloroisocyanurate exposure. Braz. J. Microbiol. 2013, 44, 785–790. [Google Scholar] [CrossRef]
- Chen, Z.; Diao, J.; Dharmasena, M.; Ionita, C.; Jiang, X.; Rieck, J. Thermal inactivation of desiccation-adapted Salmonella spp. in aged chicken litter. Appl. Environ. Microbiol. 2013, 79, 7013–7020. [Google Scholar] [CrossRef]

| Salmonella Serovars | Clin | Novo | Oxa | Pen | Van | Spec | Amo | Amp | Pip | Str |
|---|---|---|---|---|---|---|---|---|---|---|
| CC 2* | NB 5 | OX 1 | P 10 | VA 30 | 10 ug | AMC 30 | AM 10 | PIP 100 | S 10 | |
| S. Enteritidis H3527 | Res | Res | Res | Res | Res | Res | Sens | Sens | Sens | Sens |
| S. Hadar MF60404 | Res | Res | Res | Res | Res | Res | Res | Res | Res | Res |
| S. Heidelberg F5038BG1 | Res | Res | Res | Res | Res | Res | Res | Res | Res | Res |
| S. Montevideo FSIS 051 | Res | Res | Res | Res | Res | Res | Sens | S-Sens | V-Sens | S-Sens |
| S. Thompson 120 | Res | Res | Res | Res | Res | Res | Res | Res | Res | Res |
| S. Typhimurium H3380 | Res | Res | Res | Res | Res | Res | Res | Res | Res | Res |
| Process | % Injury (-) or %Enhancement (+) | ||
|---|---|---|---|
| SCA | XLD | HE | |
Sodium pyruvate trials
| +46.5 −13.7 | −94.0 −99.7 | −94.9 −98.5 |
Extended nutrient depletion/starvation
| +1.93 +16.1 +6.6 | −14.4 −99.4 −98.6 | −19.0 −99.7 −99.2 |
Acidic stress (inoculated beef, 30-sec dip)
| −4.4 +4.8 +2.7 | −95.1 −97.3 −97.9 | −96.5 −89.1 −73.0 |
Desiccation stress (salt/spiced beef, dried)
| −6.5 +17.6 +31.8 | −91.1 −96.9 −89.3 | −94.4 −95.8 −91.1 |
| Thermal stress (62.8 °C/145 °F for 75 sec) | −10.6 | −99.2 | −99.6 |
© 2020 by the authors. Licensee MDPI, Basel, Switzerland. This article is an open access article distributed under the terms and conditions of the Creative Commons Attribution (CC BY) license (http://creativecommons.org/licenses/by/4.0/).
Share and Cite
Karolenko, C.E.; Bhusal, A.; Gautam, D.; Muriana, P.M. Selenite Cystine Agar for Enumeration of Inoculated Salmonella Serovars Recovered from Stressful Conditions during Antimicrobial Validation Studies. Microorganisms 2020, 8, 338. https://doi.org/10.3390/microorganisms8030338
Karolenko CE, Bhusal A, Gautam D, Muriana PM. Selenite Cystine Agar for Enumeration of Inoculated Salmonella Serovars Recovered from Stressful Conditions during Antimicrobial Validation Studies. Microorganisms. 2020; 8(3):338. https://doi.org/10.3390/microorganisms8030338
Chicago/Turabian StyleKarolenko, Caitlin E., Arjun Bhusal, Dhiraj Gautam, and Peter M. Muriana. 2020. "Selenite Cystine Agar for Enumeration of Inoculated Salmonella Serovars Recovered from Stressful Conditions during Antimicrobial Validation Studies" Microorganisms 8, no. 3: 338. https://doi.org/10.3390/microorganisms8030338
APA StyleKarolenko, C. E., Bhusal, A., Gautam, D., & Muriana, P. M. (2020). Selenite Cystine Agar for Enumeration of Inoculated Salmonella Serovars Recovered from Stressful Conditions during Antimicrobial Validation Studies. Microorganisms, 8(3), 338. https://doi.org/10.3390/microorganisms8030338

